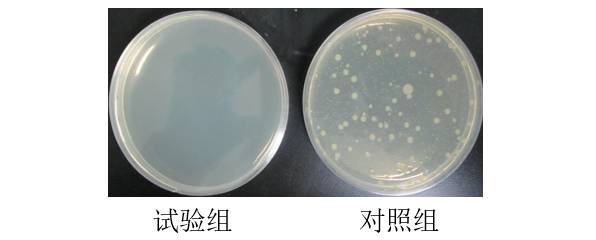
6.jpg

您好!歡迎訪問德爾塔儀器官方網站


gaoshengkeji@163.com

01簡介
1、抗菌:器具使用的材料阻礙細菌生長的百分比
針對的是洗碗機中使用的材料,比如內膽,門襯,密封條,按鍵(開關)和金屬內、外殼的表面涂層、噴淋臂等。
測試只需送材料樣塊或者從整機上裁取即可。
2、除菌:器具殺死細菌的百分比
針對的是洗碗機整機,測試需送整機。
目前洗碗機抗菌、除菌測試的標準主要有:
1、QB/T 1520-2013《家用和類似用途洗碗機》
抗菌:引用GB 21551.2-2010 《家用和類似用途電器的抗菌、除菌、凈化功能 抗菌材料的特殊要求》
除菌:本標準附錄B
2、QB/T 5133-2017《家用和類似用途洗碗機的抗菌、除菌功能技術要求及試驗方法》(2017年10月1日正式實施)
抗菌:本標準附錄A以及GB 21551.2-2010
除菌:本標準附錄B
目前洗碗機抗菌、除菌的認證項目:
1、A+認證

2、CQC認證
3、委托測試

02抗菌測試
抗菌測試包括抗細菌和抗霉菌(防霉)。
1、抗細菌測試微生物
大腸埃希氏菌Escherichia coli(ATCC 8739)
金黃色葡萄球菌Staphylococcus aureus (ATCC 6538)

2、抗細菌測試方法
(1)制備(5.0×105-10.0)×105CFU/mL的初始菌懸液;

(2)取0.2mL菌懸液分別加到試驗樣品和對照樣品上;
(3)將滅菌的覆蓋膜分別覆蓋到實驗樣品和對照樣品上;

(4)在(37±1)℃,相對濕度>90%條件下培養(24±1)h;
(5)取出培養樣品,分別加入20mL洗脫液,將試驗樣品、對照樣品和覆蓋膜上的菌液洗下,稀釋,計數。
評價指標:抗菌率
計算公式:

R:抗菌率,單位%
A:試驗樣品平均回收菌數,單位CFU/片
B:對照樣品平均回收菌數,單位CFU/片
3、防霉
菌種:黑曲霉、土曲霉、宛氏擬青霉、繩狀青霉、出芽短梗霉、球毛殼
主要方法:
(1)制備初始濃度為(0.8-1.2)×106spores/mL的孢子混合懸液;
(2)將孢子懸液充分均勻的噴到試驗樣品和對照樣品表面;
(3) 將樣品置于(28±1)℃、相對濕度(90±5)%以上的條件下培養28d。

評價指標:防霉等級

03除菌測試
1、測試微生物
大腸埃希氏菌Escherichia coli(ATCC 8739)
金黃色葡萄球菌Staphylococcus aureus (ATCC 6538)

2、測試負載(IEC 60436)

測試負載

3、測試準備
試驗前,測試樣機應空載運行除菌程序2次。
測試使用的餐具負載需干熱滅菌(160℃,2h),冷卻后備用。
4、測試污染物
10g小麥粉,100mL蒸餾水和25mL南瓜汁混合煮沸,121℃滅菌備用。
5、制備菌懸液
用0.85%的生理鹽水制備初始濃度為(109-1010)CFU/mL的菌懸液。

6、涂覆污染物
將菌懸液與污染物等體積混合均勻,涂覆到50%的個人餐具上,室溫干燥1h。
每種餐具的涂覆量如下表:

7、裝載運行
將50%污染的餐具與另外50%未污染的餐具交叉裝載于待測樣機中,運行指定的測試程序。

8、回收
用30mL無菌生理鹽水回收每套餐具上殘留的微生物,培養,計數。
9、陽性對照
將另外2套污染的餐具,在干燥后直接回收作為陽性對照。
10、陰性對照
兩個無菌處理的茶托回收作為陰性對照。
11、試驗有效性判定
陽性對照回收的微生物應不低于106 CFU/套。
陰性對照回收的微生物應不高于10 CFU/個。
12、除菌率計算

P 除菌率,%;
T0 陽性對照回收的微生物數量,CFU/mL;
T 陰性對照回收的微生物數量,CFU/mL.
04標準差異
1、抗菌

2、除菌

3、除菌對數值

R 除菌對數值.
U0 陽性對照回收微生物數量的對數值.
U陰性對照回收微生物數量的對數值.
當除菌率相同時,除菌對數值可以體現出不同結果之間的差異。

05國際標準
參與了IEC TC59/SC59 WG3洗碗機除菌性能工作組,目前工作組正在為制定洗碗機除菌國際標準進行基礎研究,針對測試菌種、污染物、是否使用洗滌劑和漂洗劑、測試表面等參數進行研究,2018年年底會有初步結論并著手起草標準草案。